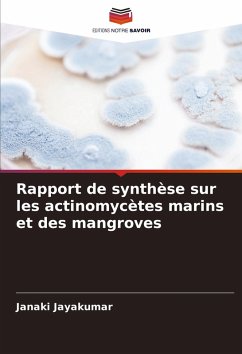

Les actinomycètes qui se développent dans des environnements très salins représentent une source importante de composés biologiquement actifs. De nombreux composés antibactériens, antifongiques, antitumoraux, cytotoxiques et photoprotecteurs ont été isolés dans ces zones. Les actinomycètes marins et des mangroves peuvent être une source de médicaments dotés d'une chimie novatrice et d'un potentiel prometteur. Étant donné que les zones marines et les mangroves sont étroitement liées, j'ai regroupé ici les travaux de recherche effectués par les autres chercheurs uniquement dans ce domaine. Le présent travail a permis de consolider les rapports disponibles sur la diversité, l'activité antagoniste, la caractérisation physiologique et biochimique, le séquençage 16sRNA et l'analyse phylogénétique, les composés bioactifs, l'activité anticancéreuse, l'activité antioxydante, l'activité larvicide sur les moustiques, l'activité kératinase et l'accumulation et la dégradation des métaux lourds. Je vous assure que ce rapport de synthèse pourrait également apporter une nouvelle dimension à votre étude sur les actinomycètes marins et des mangroves. Je remercie tous les chercheurs qui ont fait un travail remarquable dans ce domaine émergent pour une meilleure administration des médicaments à partir des actinomycètes marins et des mangroves, ainsi que pour leur contribution à notre société.
Bitte wählen Sie Ihr Anliegen aus.
Rechnungen
Retourenschein anfordern
Bestellstatus
Storno